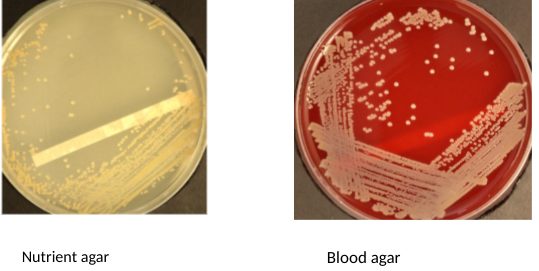
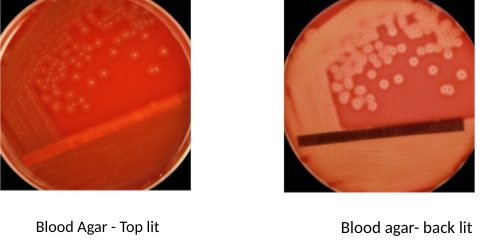
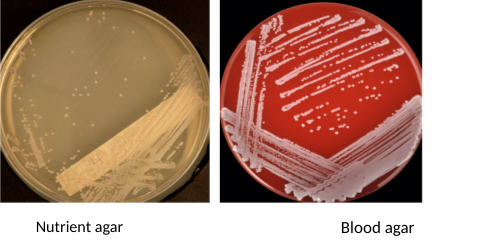
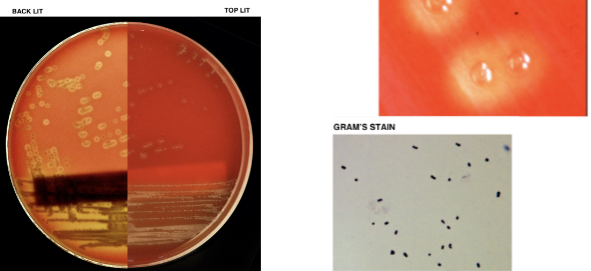
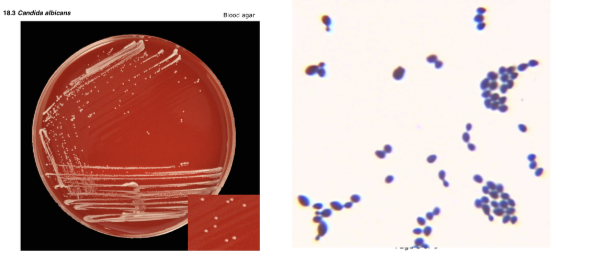
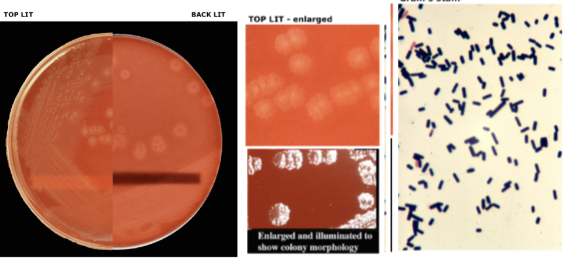
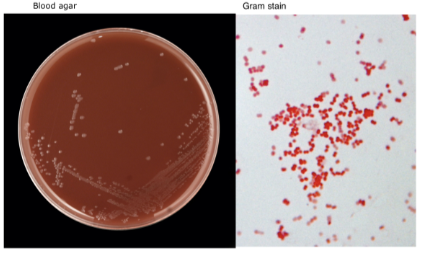
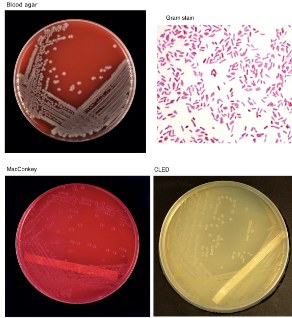
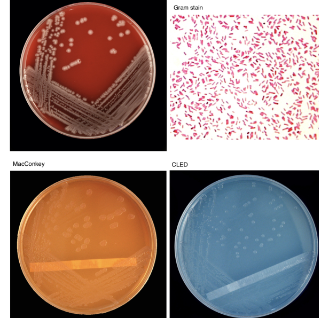

Identify:
Gram positive cocci
Spherical, in pairs or clusters
Catalase positive
Cream/yellow on agar
Coagulase positive
Staphylococcus aureus
Identify
Gram positive cocci
Spherical or ovoid in pairs or chains
Catalase negative
Complete haemolysis (β-haemolysis)
Streptococcus pyogenes
Identify
Gram positive cocci
Spherical, in pairs or clusters
Catalase positive
White on agar
Coagulase negative
Staphylococcal epidermidis
Identify
Gram positive cocci
Spherical or ovoid, in pairs or chains
Catalase negative
Incompete haemolysis (α-haemolysis)
Tiny colonies

viridians Streptococcus
Identify
Gram positive cocci
Spherical or ovoid, in pairs or chains
Catalase negative
Incomplate haemolysis (α-haemolysis)
Sunken centres
Streptococcus pneumoniae
Identify
Gram positive
Very large cells
Candida albicans
Identify
Gram positive bacilli
Aerobic
Green stain with Albert’s method

Corynebacterium diptheriae
Identify
Gram positive bacilli
Anaerobic
Small, irregular

Clostridium sporogenes
Identify
Gram positive bacilli
Anaerobic
Wispy

Clostridium tetani
Identify
Gram positive bacilli
Anaerobic
Rough ended, volcano shaped
Clostridium perfringens
Identify
Gram negative cocci
Neisseria pharyngis or Neiserria gonorrhoeae
Identify
Gram negative bacilli
MacConkey red
Faculative anaerobe
Large, creamy colony with watery edges
Escherichia coli
Identify
Gram negative bacilli
MacConkey pale
Faculative anaerobe
Salmonella
Identify
Gram negative bacilli
Green
Obligate aerobe
Pseudomonas aeruginosa
Identify
Gram negative bacilli
Anaerobic

Bacteroides fragilis


